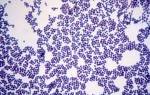

О чем говорят лейкоциты при молочнице?

Забегая наперед, можно сразу же сказать, что лейкоциты при молочнице всегда повышены. Их уровень специалисты определяют, когда берут мазок из влагалища для лабораторных исследований.
Как известно каждой женщине, одной из диагностических процедур в рамках гинекологического осмотра является забор микрофлоры влагалища. Подобное исследование позволяет врачу судить о развитии воспалительных процессов в органах половой системы.
Если пациентка здорова, то во влагалище содержится палочковая флора и незначительное число лейкоцитов. Нормальным считается показатель, не превышающий значение в 15 ед.
Если было выявлено, что он выше, то это является признаком каких-либо половых инфекций и процессов патологического характера, включая молочницу.
Признаки и причины вагинального кандидоза
При вагинальном кандидозе пациентки, как правило, жалуются на возникновение чувства зуда и жжения во влагалище и появление из половых путей белых выделений, которые имеют творожистую консистенцию.
При этом чувство зуда и жжения становится более интенсивным после водной процедуры, полового контакта либо когда женщина спит.
Если в патологический процесс будут вовлечены мочевые пути, то разовьется расстройство мочеиспускания.
Что же приводит к развитию всех видов молочницы, включая вагинальный кандидоз? Как отмечают специалисты, грибки Кандида способны присутствовать в организме в латентном состоянии довольно длительное время.
И женщина может даже ничего не знать и не подозревать об их существовании до тех пор, пока не сыграют роль провоцирующие факторы, приводящие к активному размножению грибка и развитию заболевания. В данном случае роль такого катализатора отводится ослабленной иммунной системе.
Вместе с тем в качестве предрасполагающих к развитию недуга факторов можно назвать:
- патологии органов половой системы;
- инфекционные заболевания в хронической форме;
- патологии эндокринной системы;
- нарушенный метаболизм;
- период вынашивания ребенка;
- прием антибиотических и антидиабетических препаратов, цитостатиков и кортикостероидов;
- прием гормональных противозачаточных средств;
- травмы химического либо механического характера;
- перенесенные операции;
- проживание в странах с жарким климатом;
- вирус иммунодефицита человека.
Подготовка к анализу на микрофлору влагалища
Для того чтобы поставить окончательный диагноз, лечащий врач будет руководствоваться существующей симптоматикой и результатами лабораторных исследований. Как уже было отмечено ранее, основным лабораторным методом выявления у прекрасной половины человечества гинекологических патологий является мазок на флору влагалища. Точность результатов подобных исследований составляет 95%.
Специалисты рекомендуют регулярно посещать гинеколога не реже 1 раза в течение полугода, даже если отсутствуют какие-либо тревожные симптомы.
Консультироваться у женского врача необходимо после приема антибиотических препаратов, на этапе планирования беременности, а также после рождения ребенка.
Получить максимально точный результат исследований флоры влагалища позволят следующие меры, предпринимаемые до сдачи анализов:
- отказ от половой связи за 1-2 суток до планируемой даты сдачи;
- отказ от спринцевания за 2 дня до предполагаемой даты сдачи анализа;
- за 1 сутки до того, как сдать мазок на исследование, запрещается применять свечи, вагинальный крем либо таблетки;
- за несколько часов до похода к врачу следует воздержаться от мочеиспускания;
- за день до приема у врача следует подмываться водой комнатной температуры без применения мыла.
Специалисты рекомендуют отправляться в лабораторию в течение первых дней после менструаций либо перед тем, как они начнутся. Гинекологический мазок позволяет специалистам судить о составе микрофлоры влагалища, шейки матки, а также мочеиспускательного канала.
Исследование гинекологического мазка наряду с другими составляющими позволяет выявить уровень лейкоцитов. Показатели нормы будут зависеть от участка забора биологического материала.
Так, в урине их должно быть от 0 до 10, во влагалище нормой считается значение от 0 до 15. Если говорить о цервикальном канале, то тут нормой является показатель уровня лейкоцитов от 0 до 30.
В период беременности объем белых кровяных телец может возрасти от 15 до 20.
Вместе с вышеуказанным показателем специалисты лаборатории исследуют мазок на наличие грибка Кандида в биоматериале. Он может и вовсе отсутствовать. Однако в случае выявленного увеличения числа грибков пациентке ставится диагноз молочница.
В общем и целом, выявленный лейкоцитоз является признаком развития воспалительного процесса в организме. Повышенный уровень белых кровяных телец в гинекологическом мазке свидетельствует о развитии недугов органов половой системы, классифицировать которые можно следующим образом:
- патологии неспецифического характера, включая стафилококк, микоплазму, уреаплазму, кандидоз и т. п.;
- заболевания инфекционной и вирусной природы, включая ВИЧ, хламидиоз, сифилис, гонорею и герпес;
- заболевания органов малого таза воспалительного характера, в том числе эндометрит, вульвит, цервицит и т. п.
Лечение молочницы
В случае выявленного вагинального кандидоза пациентке следует обратиться с результатами исследований к врачу за получением назначений. Лечить указанное заболевание следует в обязательном порядке. В противном случае данная патология сможет оказать влияние на репродуктивную способность женщины и на нормальное развитие и вынашивание ребенка.
На сегодняшний день фармацевтическая промышленность готова предложить женщинам массу средств для избавления от вагинального кандидоза. Действие этих препаратов направлено на то, чтобы быстро и надолго забыть о симптомах вагинальной молочницы.
Если заболевание протекает легко, то можно прибегнуть к помощи препаратов местного действия, которые производятся в виде таблеток и свечей. Самыми распространенными средствами подобного типа являются: Пимафуцин, Флуконазол, Тержинан и др. Применять указанные препараты необходимо исключительно по инструкции.
И не стоит назначать их себе самостоятельно. В данном случае необходима консультация лечащего врача.
Когда заболевания переходит в хроническую форму и случаются частые рецидивы, следует использовать препараты, обладающие противогрибковым и антибактериальным свойствами. Назначать подобные средства должен врач после проведенного осмотра.
Вагинальный кандидоз является весьма неприятным заболеванием, способным привнести в жизнь женщины массу проблем. Не стоит ждать появления очевидных признаков развития заболевания.
Лучше, как и было сказано выше, каждые полгода посещать гинеколога и проходить необходимый осмотр, а также сдавать соответствующие анализы, включая анализ мазка на определение уровня белых кровяных телец.
Выявление недуга на ранней стадии позволит максимально эффективно бороться с заболеванием.
Источник:
Лейкоциты при молочнице у женщин в крови и в моче

12.04.2017
Проведение гинекологического исследования на микрофлору влагалища дает возможность определить наличие возможных процессов воспалительного характера в половой сфере.
Если все в норме, то влагалище должно содержать палочковую флору и единичное количество лейкоцитов. Говоря про лейкоциты в мазке, то в норме показатель не должен превышать 15.
Если цифра оказалась выше, то это свидетельствует о развитии половых инфекций либо различных патологических процессов, в том числе и молочницы.

Если есть подозрения на кандидоз, то у женщины возникают симптомы, свидетельствующие о заболевания. Необходимо знать не только то, какие симптомы бывают при молочнице, но какие причины ее возникновения и как выглядит заболевание в целом.
В первую очередь следует отметить то, что при молочнице у женщины могут быть самые разнообразные симптомы, в зависимости от места расположения и стадии заболевания. А вот то, каким образом будет выглядеть заболевание, будет полностью и целиком зависеть от ее формы.
Грибок кандидоза может иметь овальную или круглую форму. Он размножается способом почкования, но может иметь свою тенденцию к образованию спор. При молочнице влагалища, женщина может наблюдать обычные слизистые выделения на начальной стадии.
Если не начать своевременное лечение, выделения становятся «творожными» и приобретают белый цвет. Женщина начинает испытывать дискомфорт, так как на фоне выделений может также появиться сильное жжение или зуд. В некоторых случаях неприятные ощущения становятся сильней во время мочеиспускания или курения.
Необходимо помнить про то, что в некоторых случаях симптомы отсутствуют, поэтому сдавать лейкоциты при молочнице станет отличным способом на выявление заболевания. Организм любого человека является уникальным, он может по-своему переживать заболевание и бороться с ним.
Если у женщины имеется такое заболевание, как кандидоз, ей придется забыть про интимную жизнь. Если молочница будет находиться в запущенной стадии, не проводя необходимое лечение, то последствия заболевания могут быть весьма плачевными. В некоторых случаях, при наличии молочницы женщина замечает кровавые выделения из влагалища в промежутках между месячными.
Что означают повышенные лейкоциты?
Высокий показатель лейкоцитов в крови должен рассматриваться совместно с бактериальной флорой влагалища.
Негативный мазок может быть двух видов:
- число лейкоцитов – 30-40, флора в большей степени кокковая;
- большой показатель лейкоцитов, отсутствие лектобацилл, в микрофлоре могут находиться разнообразные микроорганизмы, могут выделяться гонококки и трихомонады.
Проведение непосредственно мазка на флору не способно определить главные причины высоких лейкоцитов и изменений в микрофлоре. При этом он указывает на наличие в половых органах заболеваний воспалительного характера.
Если повышены лейкоциты, для диагностики возможных болезней, необходимо пройти дополнительные лабораторные анализы – мазки на онкоцитологию и бактериальный посев, кровь на наличие в организме скрытых инфекционных заболеваний. Для определения состояния эндометрия рекомендуется пройти кольпоскопию.
Лейкоцитоз свидетельствует о наличии в организме воспалительного процесса. Повышенное число лейкоцитов в мазке у женщины говорит о наличии болезней половой системы, которые можно классифицировать так:
- неспецифические: стафилококк, микоплазма, уреаплазма, кандидоз;
- инфекционные и вирусные: ВИЧ, сифилис, хламидиоз, трихомониаз, герпес, гонорея;
- воспалительные болезни органов малого таза и нижних отделов: параметрит, эндометрит, эндоцервицит, вульвит, кольпит, цервицит.
Если говорить про течение болезней, то они могут иметь острую стадию или хроническую, которая протекает без симптомов.
Повышенные лейкоциты при беременности
В результате гормональных перестроек в организме во влагалищной микрофлоре женщины при беременности наблюдается повышенный уровень лейкоцитов. При этом в норме он не должен превышать более 20 лейкоцитов в мазке.
Если при беременности мазок оказался негативным, то это может указывать на наличие в половой системе воспалительных процессов и необходимость прохождения дополнительных обследований.
Повышенные лейкоциты при наличии беременности указывают на наличие цервицита, молочницы, причинами которых становится нарушение ведения привычного образа жизни, изменения в гормональном фоне, утомляемость и стрессы.
Использование препаратов для лечения
Если были диагностированы воспалительные процессы в области половых органов, то рекомендуется использовать такие способы лечения:
- использование антисептических средств для спринцевания влагалища: перманганат калия, хлоргексидин, мирамистин;
- использование влагалищных антибактериальных суппозиториев: «Виферон», «Тержинан», «Гексикон», «Генферон»;
- при наличии кандидоза рекомендуется принимать внутрь противогрибковые препараты, как «Флюкостат» и «Флуконазол».
При наличии у пациентки инфекционных болезней, лечение подразумевает введение внутривенно антибактериальных средств, среди которых: «Метронидазол», «Ципринол», «Орнидазол».
Совместно с этим назначаются антисептики для спринцевания.
После окончания терапии рекомендуется пройти курс восстановительного лечения, которое направляется на заселение полезными бактериями влагалища с помощью эубиотиков: «Вагилак», «Лактобактерин», «Бифидумбактерин».
Важно знать, что из приведенных медикаментозных препаратов, необходимо принимать только по рекомендации врача. При самостоятельном лечении с помощью антибактериальных препаратов возможно появление различных побочных эффектов.
Лечение средствами народной медицины
При наличии заболеваний воспалительного характера, рекомендуется каждый день проводит спринцевание такими отварами, как:
- ложку столовую цветков календулы, ромашки, крапивы (на выбор) залить чашкой воды, дождаться кипения, снять с огня и дать настояться 30 минут. Перед тем как использовать отвар для спринцевания, его рекомендуется процедить через марлю или сито;
- измельчить 6 зубчиков чеснока и залить полутора литрами кипятка, дать постоять ночь, после чего процедить и использовать для спринцевания;
- измельчить два зубчика чеснока и залить 2 чашками горячей воды. Добавить 1.5 ложку столовую яблочного уксуса, размешать и процедить;
- при наличии молочницы: 1 дозу сухого бифидумбактерина перемешать с ложкой чайной воды и вазелина. Посуленной мазью рекомендуется пропитать тампон и ввести его во влагалище на десять часов. Продолжительность лечения 7-10 дней.
Последствия заболевания воспалительного характера
Если во время сдачи анализов было обнаружено повышение в крови лейкоцитов, то это свидетельствует о наличии инфекционных или воспалительных болезней, причем большинство из них могут не иметь никаких симптомов.
Определение причины с последующим ее устранением должно проводиться мгновенно. В противном случае, у женщины могут возникнуть проблемы со здоровьем.
В результате воспалительных процессов могут возникнуть последствия:
- миома матки;
- спаечные процессы, становящиеся причиной бесплодия;
- сбои в менструальном цикле;
- онкология;
- эндометриоз;
- осложнения при беременности;
- внематочная беременность;
- бесплодие.
С целью профилактики, а также последующего определения заболевания органов половой системы, рекомендуется посещать гинеколога для осмотра каждые полгода. Это позволит определить своевременно заболевание и начать его быстрое лечение.
При молочнице наблюдается повышение лейкоцитов в крови. Это необходимо знать во время сдачи анализов.
Если вы заподозрили у себя первые признаки молочницы, рекомендуется сразу же обратиться к врачу, ведь отсутствие своевременного лечения может стать причиной серьезных последствий со здоровьем. Берегите свое здоровье, не пренебрегайте своевременным посещением врачей.
Источник:
Повышены ли лейкоциты в мазке при молочнице

Большая часть населения Земли даже и не подозревает про наличие такого распространенного недуга, как молочница, или кандидоз. Особенно не обращают внимания на такое заболевание мужчины, продолжая оставаться длительное время разносчиками инфекции.
Каким образом можно определить наличие заболевания молочницей знают не многие, однако такие способы существуют. Одним из таковых способов является сдача мочи на лейкоциты. Лейкоциты при молочнице практически всегда будут повышены, что говорит о борьбе организма с инфицированием.
Более подробно об этом узнаем из материала.
Признаки и причины возникновения кандидоза
Вагинальный кандидоз являет собой одно из наиболее распространенных недугов, проявляющееся четко у женщин, и очень слабо у мужчин. При этом стоит отметить, что случаи проявления кандидоза у женщин и мужчин практически одинаковы, только мужчины гораздо реже посещают медицинских специалистов, нежели женщины гинеколога.
Главными факторами вагинального кандидоза выступают симптомы зуда и жжения во влагалище, а также возникновение творожистой консистенции, выделяющейся из промежности. Симптомы зуда и жжения повышаются после приема душа, полового контакта и во время сна.
Женщины, при обнаружении таковых симптомов, рано или поздно обращаются к врачу, который ставит диагноз и назначает соответствующее лечение.
Если своевременно не посетить врача и проводить самолечение, то в патологический процесс могут быть вовлечены органы мочеиспускания.
Причины развития кандидоза самые разнообразные, но наиболее частой из них врачи называют ослабление защитных свойств организма. В организме человека проживает определенное количество не только полезных, но и патогенных вредителей. Грибок Кандида не является исключением.
Когда иммунная система функционирует нормально, то грибок преобладает в спящем виде. Как только в организме происходит ослабление защитной функции, то количество патогенных микроорганизмов начинает преобладать над полезными бактериями.
В этот момент начинает активно развиваться грибок Кандида, приводящий соответственно к возникновению заболевания. На развитие кандидоза влияют также следующие факторы:
- Патологические отклонения органов половой системы;
- Патологические отклонения эндокринной системы;
- Инфекционные недуги хронической формы;
- Нарушение метаболизма;
- Период беременности, во время которого женский организм является более уязвимым.
Защититься от возникновения молочницы очень сложно, поэтому при ее возникновении следует немедленно прибегнуть к лечению. Несвоевременное лечение молочницы может способствовать развитию серьезных осложнений половой системы, в том числе и бесплодия.
Мазок на флору при молочнице
Чтобы диагностировать кандидоз, специалист опирается не только на клиническую симптоматику заболевания, но еще и на результаты соответствующих анализов.
Одним из наиболее распространенных видов анализов для определения признаков кандидоза является взятие мазка на флору. Эффективность данного метода для диагностирования недуга равняется 95%.
При молочнице уместен рост лейкоцитов в мазке, что свидетельствует о включении защитных свойств при борьбе с патогенными микроорганизмами.

Отсутствие симптоматики кандидоза еще вовсе не означает, что женщина не имеет признаки заболевания. Сдача мазка на флору позволяет гинекологу получить точные сведения о состоянии половой системы. При сдаче мазка на флору женщине требуется пройти некоторую подготовку:
- За несколько дней до сдачи мазка нужно исключить любые половые контакты с партнерами;
- Исключить проведения спринцеваний за 2 дня до обращения к специалисту;
- Прекратить использование свечей, таблеток и кремов;
- За пару часов до обращения к врачу исключить мочеиспускания;
- Провести подмывание водой без применения мыла и прочих химических веществ.
Посещать специалиста рекомендуется сразу после окончания месячных или же непосредственно перед тем, как они должны начаться. Чтобы осуществить забор мазка из уретры, прибегают к применению ложки Фолькмана.
Из влагалища забор осуществляется с помощью стерильного тампончика, а из шейки матки – шпателем Эйра. Суть такого анализа состоит в том, чтобы подсчитать число различных микроорганизмов и лейкоцитов.
Лейкоциты в мазке при молочнице определяются при помощи подсвечивания их специальными красителями.
Число лейкоцитов прописывается в результатах анализов. Нормированное значение лейкоцитов зависит от того, откуда осуществлялся забор материала. Нормальными значениями количества лейкоцитов для различных мест забора являются:
- В моче их число равняется от 0 до 10;
- Во влагалище – от 0 до 15;
- В цервикальном канале – от 0 до 30;
При беременности число лейкоцитов может быть увеличено до значения в 15-20. Помимо этого, в составе анализа могут обнаруживаться следующие составляющие:
- Слизь;
- Участки плоского эпителия;
- Лактобациллы;
- Лептотрикс;
- Грамотрицательные бактерии.
В норме грибки Кандида могут и не обнаруживаться при взятии анализов, но если их количество увеличивается, то врач диагностирует молочницу.
О чем говорит повышенное число лейкоцитов в моче
Для диагностирования кандидоза специалист может направить пациента на сдачу анализов мочи. При воспалениях обнаруживается повышенное значение лейкоцитов. Лейкоциты в моче при молочнице также повышаются, и поэтому, чем острее недуг, тем больше будет численность этих белых телец.
Лейкоциты при молочнице в моче предшествуют тому, что организм ведет активную борьбу с инфекцией. Численность белых кровяных телец возрастает в крови, и посредством кровотока происходит их распространение по всему организму. Эти тельца распространяются и проникают в слизистые различных органов, а также и в мочу.
Высокое число лейкоцитов в крови является очень опасным при вынашивании ребенка. Это обусловлено тем, что мать имеет один кровоток с ребенком, поэтому возникает риск внутриутробного инфицирования плода. В период вынашивания малыша женщины должны сдавать мазок на флору регулярно. При обнаружении повышенного числа лейкоцитов врач назначает соответствующее лечение.
Отсутствие соответствующей симптоматики, но выявление в моче высокого количества лейкоцитов предшествует тому, что у женщины формируется кандидоз. Отсутствие дискомфорта еще вовсе не означает, что женщина не заражена грибком Candida. Этот паразит может обитать в организме длительное время и при этом не проявлять себя.
Источник:
О чем свидетельствует повышение лейкоцитов при молочнице — территория женской безопасности

Одной из распространенных болезней влагалища является кандидозный вульвовагинит.
Рост показателей заболеваемости молочницей во всем мире связан с негативным воздействием окружающей среды на женский организм (ухудшающаяся экологическая обстановка, повсеместное применение химических средств, длительный, неоправданный прием антибактериальных препаратов, кортикостероидов, постоянный стресс). Лейкоциты при молочнице являются показателем степени сложности течения болезни. Поэтому важно регулярно посещать гинеколога, чтобы своевременно начать лечение, не допустив перехода болезни в хроническую стадию.
Кандидоз был известен еще во времена Гиппократа – тогда-то его начали называть «молочницей».
Ученые подсчитали, что в течение жизни не меньше 75% женщин хотя бы раз сталкивались с кандидозным вульвовагинитом, а 40-45% переносили данное заболевание два и более раз.
Около 5% женского населения страдают от периодических обострений молочницы. В перечне инфекционной патологии частота кандидоза составляет 30-45%.
Ученые насчитывают свыше 130 видов дрожжеподобных грибков рода Candida. В 90% случаев молочницу вызывает C. Albicans. Кандиды относятся к условно-патогенным микроорганизмам, поскольку входят в состав микрофлоры многих слизистых в человеческом теле.
Вызвать кандидоз они могут только при наличии определенных условий. Благоприятной средой для обитания Candida является температура 21-37˚С. С точки зрения данного показателя, а также уровня кислотности, женские половые органы больше подходят Кандидам, чем мужские.
Однако, не смотря на это, молочнице подвергаются и мужчины.

Посещение гинеколога всегда сопровождается взятием материала со слизистой урогенитального тракта в независимости от наличия или отсутствия характерной симптоматики. Мазок открывает общую картину состава влагалищной микрофлоры – число полезных микроорганизмов, а также условно-патогенных и патогенных.
Также этот анализ позволяет увидеть количество лейкоцитов – белых кровяных клеток, осуществляющих защитные функции в человеческом организме.
Увеличение числа лейкоцитов происходит в очагах воспаления, где эти клетки буквально захватывают и пожирают инородные агенты. Если патогенных микроорганизмов оказывается слишком много, лейкоциты увеличиваются и саморазрушаются.
Именно этот процесс представлен воспалительными проявлениями: гиперемией, отечностью, ростом температуры.
Что нужно знать о мазке на флору при молочнице
При постановке диагноза «молочница» врач опирается на общую клиническую картину болезни, а также на данные результатов анализов. Основным лабораторным методом определения у женщин гинекологических заболеваний является мазок на флору. Чувствительность результатов такой методики для выявления кандидоза составляет 95%. При молочнице повышены лейкоциты в мазке.
Желательно посещать гинеколога даже не имея жалоб и характерной симптоматики раз в полугодие, а также после каждого курса антибиотиков, во время планирования беременности, на послеродовом этапе. Мазок на флору сможет дать максимально точную информацию в случае надлежащей подготовки для сдачи анализов:
- за 1 -2 суток отказаться от половых связей;
- за 2 дня перед посещением врача прекратить спринцеваться;
- за сутки до приема запрещается использовать свечи, вагинальные крема, таблетки;
- отказаться от мочеиспускания за пару часов перед посещением врача;
- накануне приема нужно подмыться теплой водой без использования мыла.
Рекомендуется отправляться на прием к специалисту в первые дни после месячных или непосредственно перед их началом.
Гинекологический мазок предоставляет информацию о составе влагалищной микрофлоры, шейки матки и уретры.
Для забора материала из уретры применяется бактериологическая петля или ложка Фолькмана, из влагалища – стерильный марлевый тампон и шпатель Эйра при взятии клеток со слизистой шейки.
На предметных стеклах мазок из уретры обозначается «U», с шейки – «С», из влагалища – «V». Суть анализа заключается в подсчитывании количества различных микроорганизмов и лейкоцитов, которые определяются специальными красителями.
В результатах анализа гинекологического мазка указывают число лейкоцитов. Норма зависима от места забора материала. Например, в моче их должно быть 0 – 5 – 10, во влагалищной среде 0 – 10 – 15, а в цервикальном канале от 0 до 30. За период беременности показатель лейкоцитов во влагалище может увеличиваться (от 15 до 20).
Также в мазке обнаруживаются: клетки плоского эпителия (норма до 10), слизь, лактобациллы (молочнокислые бактерии, во влагалище которых должно быть много), ключевые клетки (в норме должны отсутствовать), лептотрикс(анаэробные бактерии, живущие в безвоздушном пространстве), грамотрицательные бактерии, которые являются свидетельством смешанной инфекции. Candida в норме могут и отсутствовать в каждом из мест забора материала, но когда обнаруживается увеличение их числа, ставится диагноз молочница.
Что означает повышение лейкоцитов в мазке и моче при кандидозе
Помимо мазка на флору, в случае подозрения на кандидоз пациентки сдают анализ мочи. На фоне воспалительного процесса фиксируется повышенный уровень лейкоцитов. Чем острее проявляет себя заболевание, тем больше будет число белых кровяных клеток в моче (до 100 и более).
Увеличивая количество лейкоцитов, организм борется с инфекцией. Происходит это путем насыщения крови большим количеством этих клеток, которые по кровотоку распространяются по всему телу, проникая в слизистые органов и в мочу.
Высокий уровень лейкоцитов при молочнице считается опасным во время вынашивания ребенка. Ввиду того, что у матери с малышом общий кровоток, есть риск внутриутробного инфицирования. Поэтому мазок на флору проводится регулярно во время беременности, чтобы в случае необходимости можно было вовремя начать лечение.
Кандидоз не входит в перечень инфекций, передающихся половым путем. Причиной активизации этой болезни часто становится снижение иммунитета. В случае плохо поддающейся лечению болезни, частых рецидивах стоит задуматься о патологии в организме, вызывающей кандидоз.
Часто повышенный уровень лейкоцитов в моче является единственным свидетельством того, что у женщины развивается кандидоз.
В таких случаях пациентки отказываются проводить полноценное лечение, ссылаясь на отсутствие дискомфорта.
Проблема заключается в том, что молочница очень часто сопровождается сопутствующими венерологическими заболеваниями. Отказываясь начать своевременное лечение, есть риск столкнуться впоследствии с осложнениями.
Распространенным явлением считается рост числа лейкоцитов в мазке при заболеваниях репродуктивной женской системы, а также сбоях в ряде органов и систем. Среди основных причин увеличения числа лейкоцитов находятся:
- воспаление уретры (уретрит);
- воспаленные очаги в цервикальном канале (цервистит);
- воспаление придатков (сальпингоофорит);
- воспалительные процессы на поверхности слизистой матки (эндометрит);
- воспаление влагалища по типу кольпита, вагинита;
- развитие злокачественных опухолей;
- дисбактериозные явления во влагалище и кишечнике;
- инфекции, передающиеся половым путем;
Обнаружить причину скрытой инфекции могут, применяя методику ПЦР, заключающуюся в исследовании крови, мочи, характерных выделений из половых органов.
При наличии показаний после обнаружения увеличения числа лейкоцитов в мазке и моче может быть назначено бактериологическое исследование, суть которого заключается в посеве на питательную среду. С его помощью определяется родовая и видовая принадлежность Candida, а также их чувствительность к противогрибковым препаратам.
С помощью инструментального метода кольпоскопия удается выявить бессимптомные формы кандидоза. Однако этот способ не позволяет определить возбудителя.
Однозначно пациенткам стоит помнить, что в первую очередь молочница — своеобразный маркер неблагополучных процессов внутри организма. Поэтому не нужно делать упор только на лечение противогрибковыми препаратами.
Важно пройти полноценное обследование, чтобы выявить первопричину ослабления иммунитета и устранить ее. Даже возникая из-за внутренних причин, кандидоз может передаваться через секс.
Поэтому сдавать анализ на флору необходимо одновременно обоим партнерам.
Источник:
Причины повышенных лейкоцитов в мазке у женщин и способы лечения
Лейкоциты (белые иммунные клетки крови) — это кровяные элементы иммунной системы. Их задача — обеспечение защиты организма и борьба со всевозможными вредоносными микроорганизмами, бактериями, микробами, вирусами.
Они формируются в пространстве костного мозга и лимфатических узлах, но могут свободно передвигаться через стенки сосудов и перемещаются в места, где появляется потенциальная опасность. Проявляют антитоксическое и антимикробное действие.
Почему в гинекологическом мазке у женщин может быть много лейкоцитов — основные причины и особенности лечения расскажем вам далее!
Роль клеток в организме
Процесс уничтожения лейкоцитами чужеродных и опасных элементов называют фагоцитозом. Они захватывают и поглощают «врагов», затем погибают сами.
Что такое лейкоциты в мазке у женщин?
Основные их функции:
- Выработка антител для борьбы с внешними и внутренними «врагами».
- Нормализация обменных процессов и снабжение тканей необходимыми ферментами и веществами.
- Очищение организма — ликвидация болезнетворных микроорганизмов и погибших клеток лейкоцитов.
Норма, почему могут быть повышены показатели
Увеличение лейкоцитов в мазке у женщин — признак воспалительного процесса в организме.
Выяснить их уровень можно путем сдачи анализов:
- мазок на флору;
- анализ крови;
- анализ мочи.
Женщинам чаще всего назначается сдача мазка на флору.
https://youtube.com/watch?v=SaABKzKPpRA
Такое исследование позволяет выявить заболевания мочевыделительной канала, почек или мочевого пузыря; распознать воспалительный процесс в урогенитальной области.
Материал для исследования берется:
- со стенки влагалища;
- со слизистой поверхности шейки матки;
- со слизистой мочеиспускательного канала.
Нормальные показатели уровня иммунных клеток в мазке:
- из влагалища — не более 10;
- из мочеиспускательного канала — не более 5;
- из маточной шейки — не более 15.
Таблица нормы лейкоцитов в мазке у женщин и другие показатели анализа:
Во время исследования необходимо учитывать особенности:
- Число белых кровяных клеток (лейкоцитов) увеличивается после полового контакта; повышенные показатели держатся в течение 24 часов после акта.
- Повышенный уровень наблюдается во время установки внутриматочной противозачаточной спирали.
- Микротравмы стенок влагалища также увеличивают показатели.
Основными причинами повышения количества лейкоцитов в мазке у женщин являются:
- Половые инфекции, передающиеся непосредственно во время половых актов (ИППП):
- Гонорея.
- Хламидиоз.
- Уреаплазма.
- Сифилис.
- Трихомониаз.
- Микоплазма.
- Папилломавирусы.
- ВИЧ.
- Кандидоз.
- Цитомегаловирус.
- Актиномицеты.
- Генитальный герпес.
-
Бактериальный вагиноз. Такое заболевание более известно, как дисбактериоз влагалища. Возникает, когда увеличивается число патогенных микроорганизмов в вагинальной флоре.
Предпосылки к развитию заболевания — гормональные нарушения, снижения местного иммунитета или использование вагинальных свеч.
- Аллергическая реакция на гели и смазки для интимной гигиены или средства для спринцевания.
- Онкологические болезни репродуктивной системы.
Повышенное содержание белых иммунных клеток в мазке указывает на наличие следующих заболеваний:
- Кольпит — воспалительный процесс слизистых тканей влагалища.
- Цервицит – воспалительный процесс цервикального канала.
- Эндометрит – воспалительный процесс слизистой поверхности матки.
- Аднексит – воспалительный процесс яичников и маточных труб.
- Уретрит – воспалительный процесс мочеиспускательного канала.
- Дисбактериоз кишечника или влагалища.
- Онкология органов половой системы.
Симптомы повышения
Признаки, указывающие на повышение уровня лейкоцитов и развитие воспалительного процесса мочевыделительной системы:
- болезненный характер мочеиспускания;
- появление ложных позывов к мочеиспусканию;
- выделения необычной природы;
- резкий запах выделений из половых органов;
- ощущение жжения и зуда внутри половых органов;
- сбой цикла менструации;
- проблемы с зачатием;
- неприятные ощущения при половом контакте.
Воспалительный процесс может протекать без ярко выраженной симптоматики. Важно прислушиваться к малейшим отклонениям.
Большое количество у беременных
Во время беременности мазок на флору сдается обязательно, как при постановке на учет, так и до родов.
Показатели в пределах допустимой нормы — 10-20 единиц в поле наблюдения. А повышенное количество указывает на развитие воспаления.
Часто во время беременности обостряются многие заболевания, которые никак не проявляли своего присутствия до зачатия.
Происходит изменение гормонального фона, снижается иммунная защита, часто у беременных возникает молочница или кандидоз. При выявлении повышенного уровня белых кровяных клеток необходимо пройти обследование для установления точной причины воспалительного или инфекционного процесса.
Причинами повышенных лейкоцитов в мазке у женщин могут оказаться:
- Заболевания, предающиеся половым путем (уреаплазмоз, сифилис, гонорея и другие).
- Молочница.
- Вагиноз.
- Кольпит.
Врачи часто назначают препарат для укрепления местного иммунитета:
- Эхинацея.
- Иммунал.
- Элеутерококк.
- Женьшень.
Для лечения вагиноза прописывают:
- Бифидумбактерин.
- Лактовит.
- Лактофильтрум.
Высокое содержание после родов
Лейкоциты мгновенно реагируют на малейшие отклонения или изменения в работе организма. Поэтому часто их уровень повышается по физиологическим причинам. К ним относится и послеродовой период.

Во время родов женщина теряет много крови.
Для предотвращения осложнений иммунные белые клетки заранее подготавливаются к такой ситуации и скапливаются в большом количестве в области матки.
С этим связано увеличение числа их показателей в мазке после родов.
Их количество увеличивается во время начала родоразрешения и в восстановительный период. Показатели нормализуются через 4-5 дней после родов.
В таких случаях необходимо сразу обратиться к врачу.
Возможная опасность превышения
Хроническое и частое повышение уровня лейкоцитов в организме может привести к серьезным осложнениям.
Возможные риски:
- Наступление бесплодия.
- Внематочная беременность.
- Появление эрозии.
- Проявление мастопатии.
- Отклонения в работе мочевого пузыря или почек.
- Нарушение работы яичников.
- Образование спаек и миом.
Диагностика и помощь врача
При выявлении повышенного уровня лейкоцитов в мазке необходимо обратиться к врачу:
- Гинекологу.
- Дерматовенерологу.
- Инфекционисту.
Чаще всего назначаются следующие виды диагностических процедур:
- посев на флору;
- мазок на флору;
- ИФА (иммуноферментный анализ);
- анализ на антитела в крови;
- биопсия;
- ПЦР (полимеразная цепная реакция);
- ОАК (общий анализ крови);
- ОАМ (общий анализ мочи);
- УЗИ брюшной полости.
Медикаментозное лечение
Как уже отмечалось, повышение количества белых иммунных клеток может произойти из-за воспалительного или инфекционного заболевания. Лечение, проводимое при воспалении или инфекции, имеет разноплановый характер.
Лечение воспалительного процесса проводится по следующей схеме:
- Применение антисептических средств. Проводится регулярное промывание влагалища антисептиками «Мирамистином», «Хлоргексидином», «Калия перманганатом».
- Используются антибактериальные препараты. Назначаются «Генферон», «Пимафуцин», «Тержинан», «Виферон».
- Для лечения кандидоза — «Флуконазол» и «Флюкостат».
Лечение инфекционного процесса проводится по следующей схеме:
- Внутривенное применение антибактериальных средств: «Орнидазол», «Метронидазол» и «Ципринол».
- Назначение препаратов для профилактики дисбактериоза влагалища: «Бифидумбактерин», «Лактовит» и «Лактофильтрум».
Как лечить народными методами
Народные методы предполагают использование домашних отваров трав для спринцевания и приема внутрь.
Их можно приготовить по следующим рецептам:
- Залить одну десертную ложку сухой травы ромашки (можно заменить крапивой, календулой, зверобоем) стаканам кипяченой воды. Довести на слабом огне до кипения, снять с огня, настаивать полчаса. Процедить. Использовать для спринцевания влагалища.
- Можно проводить спринцевание содой. Для приготовления раствора используется половина маленькой ложки пищевой соды. Ее разводят стаканом теплом воды.
-
Полезен отвар зверобоя для приема внутрь. Одну десертную ложку травы заливают стаканом воды, кипятят четверть часа. Процеживают, принимают трижды в течение дня по 1/4 стакана.
- Из отвара сухих листьев лавра можно приготовит лечебную ванну. 20 г травы разводится в полном ведре воды. В таком отваре принимают сидячую ванну.
Чего не стоит делать
Во время лечения воспалительного процесса в области малого таза необходимо соблюдать осторожность:
- Запрещено использовать антибиотики без назначения врача.
- Нельзя использовать антибактериальные препараты во время беременности.
- Нельзя лечить инфекционный процесс противовоспалительными препаратами.
- Запрещено подмываться холодной водой.
- Нужно заменить тампоны обычными прокладками.
- Запрещено использовать средства для спринцевания на спиртовой основе.
- Нельзя допускать переохлаждения организма.
Узнайте об анализах в гинекологии: расшифровка мазка на флору у женщин, норма содержания лейкоцитов, по каким причинам возможно повышенное их содержание, расскажет специалист в этом видео:
Такой показатель — признак неполадок в работе внутренних органов и систем, указывает на развитие инфекции или воспаления.

Самолечением заниматься запрещено. При обнаружении любых отклонений в результатах анализа нужно обратиться к врачу.
Источник: